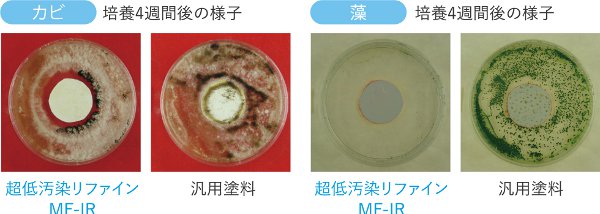
カビ・藻培養４週間後の様子

100年間家を守り続ける「100年ペイント」
「100年の間、建物を守りたい。」このコンセプトから誕生したのがアステックペイントをおすすめしています。次の塗替えまで15年~20年という私たちが大変ほれ込んだ塗料です。
アステックペイントは、契約を結んだ施工店のみ扱える業界トップクラスの塗料です。
汚れにくい「超低汚染」

汚れがつきにくく、さらに雨で汚れが洗い流される塗料!塗装したての外観をそのままに、いつまでも綺麗に保ちます

汚染性比較試験
塗膜表面をカーボンブラック分散水(排ガス等の成分)にて汚染させた後水で洗浄し、汚染前と汚染後の明度の差を計測しました。
その結果、超低汚染リファインシリーズは他社の塗料と比較し、明度の低下が非常に小さく、低汚染性に優れていることが確認されました。

超低汚染性リファインシリーズの汚れにくさを動画でチェック!
付着した汚れを雨水が洗い流す為、汚れが定着しにくいのです。
防カビ・防藻性付き!
「JIS Z 2911 かび抵抗性試験」および「藻抵抗性試験(※社内試験)」に合格。
美観保持力の向上につながるとともに、アレルギーへの原因にもなるカビを抑制する、健康にも優しい塗料です。
雨漏り対策をしたいかたへおすすめ

防水だけでなく遮熱性能もプラスされた高性能塗料です。塗るだけで、超弾性力と防水機能、遮熱、断熱仕様が実現できるピュアアクリル。次の塗替えまで15年~20年という私たちが大変ほれ込んだ塗料です。
最高レベルの防水効果に加え、耐候性と遮熱性を併せ持つピュアアクリル塗料。雨漏りから建物を長期的に守りたい方には特にオススメの塗料です。
伸びる塗料

大切な家を長持ちさせたいという思いから誕生した「伸びる塗料」でお家への水の浸入を防ぎます!
防水性

一般塗料では、外壁にヒビが入ると塗膜も一緒に裂け、建物内に水が浸入してしまいますが、対してピュアアクリル塗料は、伸縮する塗膜が追随し、水を浸入させません。
耐候性 - 期待耐用年数15年以上。
促進耐候性試験(スーパーUV)600時間(15年以上)をクリアー。
フッ素樹脂塗料と同等の耐候性を持ち、塗替え後の光沢を長期間保持する。
-
樹脂が大きく、紫外線に強い
一般的なアクリル樹脂の約50~100倍大きいため、紫外線により破壊される樹脂破壊ポイントが少なくなり、高い耐候性を保持します。

-
有機ガラス配合
有機ガラス配合でさらなる耐候性を実現。有機ガラス成分(ポリカーボネート樹脂:電気製品や自動車など多くの工業製品に使用)をブレンドし、さらに耐候性を高めています。
